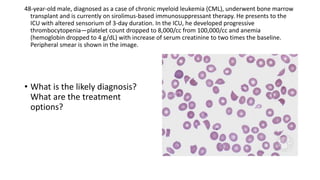
48-year-old male, diagnosed as a case of chronic myeloid leukemia (CML), underwent bone marrow
transplant and is currently on sirolimus-based immunosuppressant therapy. He presents to the
ICU with altered sensorium of 3-day duration. In the ICU, he developed progressive
thrombocytopenia—platelet count dropped to 8,000/cc from 100,000/cc and anemia
(hemoglobin dropped to 4 g/dL) with increase of serum creatinine to two times the baseline.
Peripheral smear is shown in the image.
• What is the likely diagnosis?
What are the treatment
options?
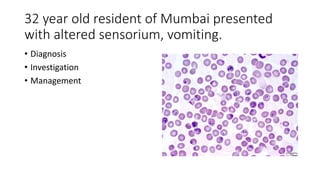
32 year old resident of Mumbai presented
with altered sensorium, vomiting.
• Diagnosis
• Investigation
• Management

This document contains multiple questions asking to identify medical devices, procedures, and patient scenarios. For each, the responder is asked to identify the device/procedure/scenario, indicate relevant indications or contraindications, and describe management steps or potential complications. The questions cover a wide range of topics including imaging tests, laboratory investigations, medical procedures, ventilation devices, and patient presentation.